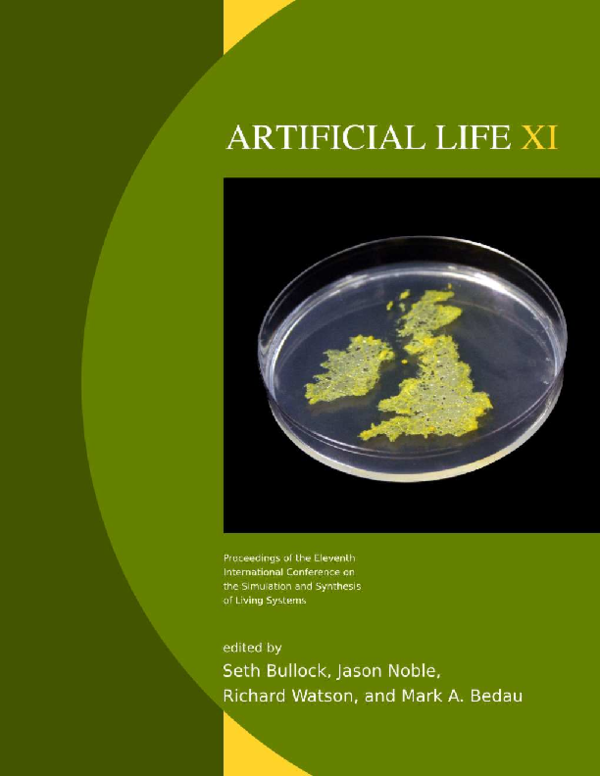

Искусственная жизнь определение
Выполнение проверки съемного носителя
Центрофинанс микрозайм на карту
Чага магазин
Иллюстрация к любой былине 6 класс
Ата аналар жиналысының тақырыптары
Крупнейший ледник альпийских гор
Изменение курса евро к рублю
Песня good morning для детей на английском
В лорето
Till the end песня фонк
Play 60 plus
Ltd explorer
Как сохранить помидоры снятые зелеными
Искусственная жизнь определение 114 фотографий